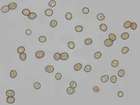

Verwandte Arten
Pluteus atricapillus (Batsch) Fayod 1889
Pluteus atromarginatus (Singer) Kühner 1935
Pluteus aurantiorugosus (Trog) Sacc. 1896
Pluteus boudieri P.D. Orton 1972
Pluteus brunneidiscus Murrill 1917
Pluteus brunneoradiatus Bonnard 1987
Pluteus caloceps G.F. Atk. 1909
Pluteus carneipes Kühner 1950
Pluteus cervinus f. pseudovelatus E. Ludw. 2007
Pluteus cervinus (Schaeff.) P. Kumm. 1871
Pluteus cervinus var. albus Peck 1885
Pluteus chrysophaeus (Schaeff.) Quél. 1872
Pluteus chrysophaeus var. cyanopus (Quél.) Quél. 1888
Pluteus chrysophlebius (Berk. & M.A. Curtis) Sacc. 1887
Pluteus cinereofuscus J.E. Lange 1971
Pluteus cinereus Quél. 1884
Pluteus coccineus (Massee) J.E. Lange 1937
Pluteus curtisii ss. Singer
Pluteus cyanopus Quél. 1883
Pluteus depauperatus Romagn. 1956
Pluteus dianae Pilát 1968
Pluteus diettrichii Bres. 1905
Pluteus diettrichii f. poliocnemis (Kühner) E. Ludw. 2007
Pluteus drepanophyllus Kalchbr. 1875
Pluteus dryophiloides P.D. Orton 1969
Pluteus atromarginatus (Singer) Kühner 1935
Pluteus aurantiorugosus (Trog) Sacc. 1896
Pluteus boudieri P.D. Orton 1972
Pluteus brunneidiscus Murrill 1917
Pluteus brunneoradiatus Bonnard 1987
Pluteus caloceps G.F. Atk. 1909
Pluteus carneipes Kühner 1950
Pluteus cervinus f. pseudovelatus E. Ludw. 2007
Pluteus cervinus (Schaeff.) P. Kumm. 1871
Pluteus cervinus var. albus Peck 1885
Pluteus chrysophaeus (Schaeff.) Quél. 1872
Pluteus chrysophaeus var. cyanopus (Quél.) Quél. 1888
Pluteus chrysophlebius (Berk. & M.A. Curtis) Sacc. 1887
Pluteus cinereofuscus J.E. Lange 1971
Pluteus cinereus Quél. 1884
Pluteus coccineus (Massee) J.E. Lange 1937
Pluteus curtisii ss. Singer
Pluteus cyanopus Quél. 1883
Pluteus depauperatus Romagn. 1956
Pluteus dianae Pilát 1968
Pluteus diettrichii Bres. 1905
Pluteus diettrichii f. poliocnemis (Kühner) E. Ludw. 2007
Pluteus drepanophyllus Kalchbr. 1875
Pluteus dryophiloides P.D. Orton 1969

Bitte wechseln Sie zu einem Bundesland, um detailliertere Darstellungen für einzelne Fundstellen einzusehen oder eine genauere Karte zur Weiterverwendung zu beziehen.
Pluteus thomsonii (Berk. & Broome) Dennis 1948
Synonyme: Pluteus cinereus Quél. 1884
Systematik: Basidiomycota > Agaricales > Pluteaceae
Deutscher Name: Graustieliger Adern-Dachpilz
Bitte registrieren Sie sich kostenlos auf den Seiten, damit Sie auf alle Informationen und Fundstellendaten zu den Arten Zugriff erhalten und die volle Funktionalität der internetseite nutzen können: